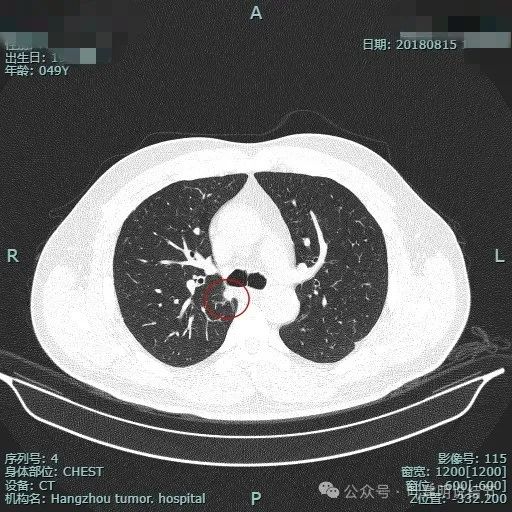
图片

前言:临床上许多时候对于肺小结节到底该不该手术,确实也会较难抉择。特别是实性结节又有恶性影像特征,但它随访却进展非常缓慢的话,手术怕良性,随访怕恶性。那我们应该如何来考虑与权衡呢?今天分享的这个病例,患者查出肺结节已经7了,之前都在随访,由于病灶不大,开始并不太担心,但前段时间查了次PET-CT,发现此病灶代谢轻度增高,这就又无比纠结了,到底开不开刀,杭州市第一人民医院的多学科讨论到底是如何来权衡与决策的,与大家分享。
病史信息:

七年前检查发现肺结节,期间随访,近期查了PET,提示右上结节葡萄糖代谢轻度增高,考虑低代谢肿瘤性病变可能性大。
影像展示与分析:
我们先来看2024年4月的病灶影像:

病灶出现,位于右上叶靠近肺门侧,此层显得像磨玻璃密度,轮廓较清。

其实应该实性密度的,前面层面应该是较为边缘部位的关系。病灶表面有点毛糙。

结节毛刺明显,而且是细毛刺。

有微血管走向病灶,结节与纵隔侧紧贴,但胸膜牵拉不明显。

有明显血管征,而且进入的血管是弯曲改变走行的。

表面不平显毛糙,有细毛刺。

此层显得病灶缺乏膨胀性,边缘较为平直。

边缘区较淡,也显得有点散。

病灶没有钙化。

纵隔窗可见。
影像初考虑:
右上这个病灶如果是首次发现,要怀疑恶性的可能性大于良性,因为有毛刺与血管征,表面不平,而且这种实性密度的,若是恶性还是风险比较高的。
既往影像展示:
先看2017年初发现时的:

2017年8月时此灶就有,而且也是实性的,大小相差不多,最大层面现在的似乎略有饱满点。
再看2018年时连续层面的:

病灶出现。

实性密度,边缘略糊。

表面毛刺。

紧贴胸膜。

血管进入。
整体轮廓较清。

细毛刺明显。

缺乏膨胀性。

边缘区密度较淡。
影像再考虑:
这个病灶前后相差7年时间,说不上明显进展,但总体上看,一是实性密度;二是边缘毛刺;三是血管征明显;四是多年也没有钙化或挛缩成纤维增殖灶。感觉虽然由于进展不明显,良性的可能性大些,但基于以上因素,恶性仍不能除外,当然真若恶性,则恶性程度肯定也不高。所以查下PET-CT看看代谢是否有增高是重要的手段,若是代谢有增高则倾向交界性或低度恶性肿瘤;若代谢无增高,则考虑良性可继续随访。
PET-CT检查情况:




PET检查结果示右肺上叶后段小结节,葡萄糖代谢轻度增高,考虑低代谢肿瘤性病变可能性大。
多学科讨论意见:
右上叶病灶持续存在,实性密度,多年无钙化或挛缩成疤痕的表现,CT影像上表面不平有细毛刺,也有典型的血管进入,加上PET-CT提示有存在代谢轻度增高情况。但基于长达7年无显著进展,总体更倾向良性些。但由于患者思想负担重,PET又说代谢存在增高,加上病灶位置在边缘,若是良性,大概率能够适当游离后局部切除,建议与患者充分沟通后予以手术探查并切除,但尽量避免肺段或肺叶切除。
最后结果:
杭州市第一人民医院胸外科叶建明团队在江洪主任指导下进行了胸腔镜下微创手术。进胸后发现病灶颜色色,质地硬,肉眼看像是纤维增殖灶或纤维化淋巴结的样子,予以解剖分离与周围组织的粘连,避免损伤奇静脉以及肺血管。但手术中发现无法将病灶处提起来予以用切割缝合器离断,遂超声刀沿病灶予以切除,肺粗面用无创伤线予以缝合。手术顺利,术后恢复好。

表面观病灶漆黑,质硬。

剖面也是墨黑的,不像肿瘤或肉芽肿。
病理报:纤维增生变性结节伴硬化、钙化及组织细胞反应。
感悟:
肺结节实性密度,随访影像上未见钙化,又有恶性影像特征,加上PET代谢存在增高,即使是轻度,仍真不能完全交界性或低度恶性肿瘤。这种情况若病灶位于肺外周,能楔形切除或局部病灶切除,肺功能受损不明显,仍以取向病理依据明确诊断为妥。而若病灶位置肺叶中央无法局部切除,要切除肺叶才能取向病理的,则基于随访并无显著进展,应该再观察随访更为稳妥。当然此例若患者思想负担不重,若仍半年复查随访也是可行的,但从去除了病灶、明确了诊断、解除了顾虑来说,微创手术,且几乎没有肺功能的损失,仍是可以选择的。
